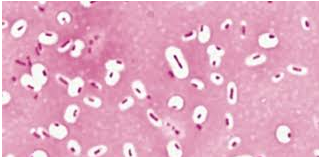
<p><span style="background-color: transparent;"><span>are a gelatinous cover DOES NOT ACCEPT MOST DYES&nbsp;</span></span></p>

staining
1/24
There's no tags or description
Looks like no tags are added yet.
Name | Mastery | Learn | Test | Matching | Spaced |
|---|
No study sessions yet.
25 Terms
Staining
coloring microorganisms with a dye that empathizes certain structures

Smear
a thin film of material containing microorganisms spread over a slide


Fixing
smear must precede staining:
Attaches microorganisms to the slide
Kills the microbes
Basic dyes
chromophore cation
Crystal violet, methylene blue, safranin

what charge do bacteria have
Bacteria have negative charges so basic, so dyes adhere to them


what dye is used for simple staining
Crystal violet
Safrain
methylene blue
Mordant
used to hold the stain or coat the specimen to enlarge
what is simple staining used for
Use to high the cell for visual shapes and structure
Differential stain used for
Distinguish between bacterial/cells
Differential stain used to detect
presence or absence of structures: special stain
endospores , flagella, capsules
what does Gram Stain do
detect bacteria in clinical specimens, Often the first step used to id bacteria, Can be used valuable for treatment, Bacteria need to young a actively growing
Gram-positive: bacteria
Thick peptidoglycan cells walls
Gram-negative: bacteria
Thin peptidoglycan cell walls and an outer membrane of lipopolysaccharides and phospholipids
Acid-fast stain
Binds to bacteria that are waxy in their cell walls which is not decolorized acid alcohol

Acid-fast stain is used to id
Mycobacterium
Nocardia
what are the Special stain
Capsule stain
Endospore stain
Flagella stain
Capsules
are a gelatinous cover DOES NOT ACCEPT MOST DYES
Capsules stain process
India ink or nigrosin contrast the background with the capsule
Cells stained with simple stain
Capsules appears as a halo around the bacterial cell
Endospore
are resistant, dormant structures that cannot be stained by ordinary methods
Schaeffer-Fulton endospore stain
1) malachite green, usually
with heat to help dye penetrate the
Endospore
2)Decolorize: water
3) Counterstain: safranin
what color are the spores appear in endospore stain
green

what color are the cells appear in endospore stain
red or pink

Flagella
structures of movement
Flagella have to be stained becuase
Too slender r and cannot be viewed with a light microscope unless stained
Flagella process
Flagellar stain uses a mordant and carbolfuchsin to thicken appearance of flagella, making them visible under the light microscope
Enables determination of the number and arrangement of flagella